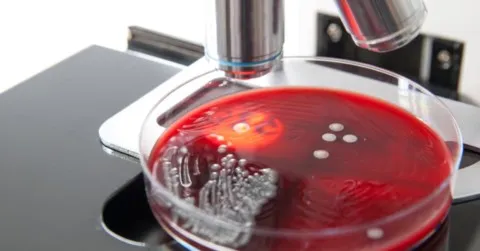
agarplatta med bakterier

2025 - Okt
- Utforska komplexiteten hos mykotoxiner i livsmedel
- Dödlig botulism i Italien – Broccoli återkallelse
- Så hittar du listeria i din livsmedelsanläggning
- 3M:s miljöövervakningshandbok – en resurs för branschen
- Svensk standard – Effektivt ledningsgruppsarbete – Vägledning SS 625000:2024
- Ny Handbok HACCP, TACCP & VACCP
- ISO 9001:2026 – Vad är nytt?
- MPs varnar: köttsmuggling riskerar sjukdomsutbrott
- Så blir du av med listeria i din anläggning
- Ny KursBRC Packaging 7
- Toxigena profiler hos bakteriepatogener i livsmedel
- Amish-barn och allergier – vad är hemligheten?
- IFS White Paper: Allergenhantering och märkning
- Mindre kända allergener bakom många allvarliga reaktioner
- Radioaktivt cesium i importerade räkor och kryddor
- Interna Revisioner FSSC 22000 vers 6
- Fyra dolda allergener kan bli märkta i EU
- Fusk och säkerhetsproblem med kanel i EU
- Operation OPSON: EU:s stora insats mot livsmedelsfusk
- Uppskattad Online utbildning HACCP, VACCP och TACCP
- Vibrio-infektion - köttätande bakterien som orsakar dödliga livsmedelsburna sjukdomar
- Hexanrester upptäckta i vardagliga livsmedel:fransk undersökning väcker oro
- Lär dig mer - System för TACCP och VACCP (Hot, Sabotage och Förfalskning)
- Må kiwikraften vara med dig
- FSIS Guidelines - Nya HACCP modeller
- Fågelinfluensa i mejeriprodukter
- Investera i utbildning och kompetens On-line

Hej Alla
Höstmörkret har börjat sänka sig och jag har samlat på mig en hel del nyheter sedan senast.
Jag hoppas att du hittar något som intresserar dig.
Jag kommer också inom den närmaste tiden att publicera en ny HACCP-kurs som kommer att kallas HACCP 2.0 - en kurs för dig som behöver uppdatera dina kunskaper i HACCP. Mer info om detta kommer senare.
Sist i detta nyhetsbrev en artikel om spridningen av fågelinfluensan bland mjölkkor i USA. Inte utan att man frågar sig när den muterar och även sprider sig bland människor. Har Folkhälsomyndigheten någon beredskap för vad som kan bli nästa Covid epidemi?
Lev väl
Jan
Utforska komplexiteten hos mykotoxiner i livsmedel

Vår livsmedelsförsörjning kan vara ett ganska komplext ekosystem, med mikroorganismer som svampar som kan påverka grödor och livsmedel Att föregå med gott exempel. Även om vissa svampar har en positiv inverkan, till exempel de som är viktiga för produktionen av baslivsmedel som ost och bröd kan andra vara skadliga, särskilt de som utsöndrar giftiga föreningar som kallas mykotoxiner och som kan utgöra en betydande hälsorisk för både människor och boskap.
Mykotoxiner är en av de främsta orsakerna till att livsmedel avvisas vid import av livsmedel i EU. Faktum är att Systemet för snabb varning för livsmedel och foder (RASFF) Kommittén framhåller särskilt höga nivåer av kassationer till följd av mykotoxinkontaminering i nötter, nötprodukter och frön.
Dödlig botulism i Italien – Broccoli återkallelse

En allvarlig botulismutbrott i södra Italien har lett till två dödsfall och över 14 sjukhusinläggningar efter att folk ätit smörgåsar med korv och broccoli rabe från en foodtruck. Myndigheterna har snabbt återkallat flera produkter och inlett en utredning om hur bakterien Clostridium botulinum kunde hamna i maten. Botulism är ovanligt men kan vara livshotande, särskilt om maten inte är rätt konserverad. Den italienska hälsomyndigheten har aktiverat krisrutiner och varnar för att äta mat som inte är säkert konserverad eller om burkarna ser misstänkta ut.
Läs mer här:
Så hittar du listeria i din livsmedelsanläggning

Att leta efter listeria kräver ett genomtänkt miljöövervakningsprogram (EMP) och stöd från ledningen. Det handlar om att strategiskt ta prover på rätt ställen, analysera riskzoner och ibland ta in experthjälp.
Det är viktigt att förstå att listeria kan gömma sig i svåråtkomliga nischer och att utrustningens utformning spelar stor roll. Regelbundna “swab-a-thons” och samarbete med mikrobiologiska laboratorier rekommenderas. Målet är att hitta och eliminera tillväxtzoner innan de blir ett problem.
3M:s miljöövervakningshandbok – en resurs för branschen

3M och Cornell har tagit fram en omfattande handbok för miljöövervakning inom livsmedelsindustrin. Den täcker allt från hygienkontroller till provtagning av allergener och patogener. Handboken är tänkt att hjälpa företag att skapa mer strategiska och integrerade program för att förebygga kontaminering och förbättra både säkerhet och produktkvalitet.
Svensk standard – Effektivt ledningsgruppsarbete –
Vägledning SS 625000:2024

Syftet med detta dokument är att:
- Beskriva ett strukturerat arbetssätt tillsammans med stödjande metoder och tillämpningar som kan förbättra ledningsgruppens arbete.
- Öka kvaliteten på ledningsgruppens arbete.
- Skapa en hög medvetenhet i ledningsgruppsarbetet som leder till värdeskapande och effektivitet.
Genom att följa råden i detta dokument kan ledningsgruppens förmåga att ta beslut av hög kvalitet stärkas.
Läs mer härNy Handbok
HACCP, TACCP & VACCP
HANDBOOK HACCP TACCP VACCP: Master Food Safety, Defence & Fraud – The Practical Guide for Modern Food Businesses
ISO 9001:2026 – Vad är nytt?
En ny version av ISO 9001 är på gång och väntas publiceras 2026. Bland nyheterna finns större fokus på kvalitetskultur, etik och klimatpåverkan. Kraven har förtydligats, men förändringarna är relativt måttliga. Övergångsperioden väntas bli upp till tre år. Det är klokt att redan nu börja förbereda sig och se över interna rutiner och utbildning.
Läs mer här
SGS sammanfattar att den kommande ISO 9001-versionen innebär förtydliganden kring kvalitetskultur, etik och riskhantering. De flesta förändringar är redaktionella snarare än grundläggande, men det är ett bra tillfälle att se över sitt ledningssystem och utbilda personalen i de nya kraven.
Läs mer här:
MPs varnar: köttsmuggling riskerar sjukdomsutbrott

En ny rapport från brittiska parlamentet varnar för att stora mängder illegalt kött och mejeriprodukter förs in i landet, ofta under dåliga hygieniska förhållanden. Detta ökar risken för allvarliga djursjukdomar som afrikansk svinpest och hotar både folkhälsa och livsmedelssäkerhet. Myndigheterna saknar resurser för att stoppa smugglingen och efterlyser hårdare tag och bättre samarbete.
Så blir du av med listeria i din anläggning
Listeria är svår att helt undvika, men genom rätt utbildning, noggrann rengöring och sanering, samt god utrustningsdesign kan man minimera riskerna. Separera råvaru- och färdigvaruområden, undvik trä och svårstädade ytor, och ha strikt skadedjurskontroll. Regelbunden testning och utbildning av personalen är avgörande.
Ny Kurs
BRC Packaging 7
Vad är Nytt?
Tillämpas på alla revisioner från 28 april 2025
Fokus har varit på:
- Kultur för produktsäkerhet och förhindra förfalskning
- Uppdatera kraven på faroanalys och riskbedömning i linje med Codex Alimentarius
- Kontinuerliga förbättringar och införande
- Möjligt med Blandade revisioner
- Säkerställa kvalitet/säkerhet I tillverkningen
- Termen dokumenterad borttagen
- Terminologi ändrad
Totalt mer än 167 paragrafer ändrade men mycket är förtydliganden och redaktionella ändringar, men som vanligt med BRC så gäller det att hålla koll på alla smådetaljer som ändras.
Toxigena profiler hos bakteriepatogener i livsmedel
Campden BRI har undersökt hur olika bakterier överlever och producerar toxiner i kylda, pastöriserade livsmedel. Fokus ligger på Listeria och Clostridium botulinum, men även andra bakterier som Bacillus och Clostridium kan överleva och växa vid kyld lagring. Rätt värmebehandling och formulering av produkten är avgörande för säkerheten.
Läs mer här
Amish-barn och allergier – vad är hemligheten?

Amishbarn i USA har extremt låg förekomst av allergier och astma bland barnen. Forskare tror att tidig och regelbunden exponering för mikrober i ladugårdsdamm tränar immunförsvaret att reagera lugnare på allergener. Den så kallade “farmeffekten” kan i framtiden leda till nya sätt att förebygga allergier även för stadsbarn.
Läs mer här
IFS White Paper: Allergenhantering och märkning

IFS har sammanställt referenser och vägledningar för hur företag kan arbeta systematiskt med allergenhantering och uppfylla kraven i IFS-standarden. Fokus ligger på rengöring, riskanalys och validering av rutiner för att minimera risken för oavsiktlig allergenkontaminering
Mindre kända allergener bakom många allvarliga reaktioner

Nya studier visar att ingredienser som bovete, selleri och sulfiter orsakar fler allvarliga allergiska reaktioner än man tidigare trott. Dessa “dolda” allergener finns ofta inte med på märkningen, vilket gör det svårare för allergiker att undvika dem. Forskare efterlyser bättre testning och tydligare märkning för att öka säkerheten.
Läs mer här
Radioaktivt cesium i importerade räkor och kryddor

FDA har hittat radioaktivt cesium (Cs-137) i importerade räkor och kryddor från Indonesien. Flera produkter har återkallats, och myndigheterna har infört nya importkrav för att minska risken för långvarig exponering. Ingen produkt över gränsvärdet har nått konsumenter, men händelsen visar på vikten av noggrann kontroll av importerade livsmedel.
Interna Revisioner
FSSC 22000 vers 6

- Hur känns det?
- Interna revisioner kan vara skrämmande, roliga, spännande, lärorika mm för alla inblandade.
- Hur skall jag klara att granska mina kollegor?
- Vad tycker de om mig då?
- Hur gör jag?
- Vad skall jag fråga om?
- Vad är en avvikelse?
- Vad säger standarden?
Fyra dolda allergener kan bli märkta i EU

Experter föreslår att get- och fårmjölk, bovete, ärtor/linser och pinjenötter ska ingå i EU:s lista över allergener som måste märkas ut. Dessa har visat sig orsaka fler allvarliga allergiska reaktioner än vissa redan märkta allergener. Förslaget bygger på data från nästan 3 000 anafylaxifall och kan leda till förändringar i märkningen framöver.
Läs mer här
Fusk och säkerhetsproblem med kanel i EU

En ny EU-studie visar att över 66 % av kanelproverna på marknaden inte uppfyller kvalitetskraven, ofta på grund av utbyte av äkta Ceylonkanel mot billigare Cassiakanel eller för höga halter av bly och kumarin. Flera prover var potentiellt farliga för barn. Studien lyfter behovet av bättre kontroll och standardiserade analysmetoder för att skydda konsumenterna.
Läs hela artikeln här
Operation OPSON: EU:s stora insats mot livsmedelsfusk

Årets Operation OPSON, ledd av Europol och Interpol, resulterade i beslag av mat och dryck till ett värde av 95 miljoner euro och över 100 gripanden. Fusk med utgångna produkter, felmärkning och illegal slakt var vanliga brott. Insatsen visar att organiserad brottslighet i livsmedelssektorn är ett växande problem som kräver internationellt samarbete och bättre kontroller.
Uppskattad Online utbildning HACCP, VACCP och TACCP
- "Utbildningen var väldigt lärorik och gav många nya infallsvinklar på hur man kan jobba med HACCP, VACCP, TACCP. Gav en väldigt bra fördjupning i ämnet. Kan starkt rekommendera denna kurs."
- "Jag tycker att denna utbildning är riktigt bra! Jag kommer att rekommendera denna utbildning till mina kollegor! Utbildningen borde även finnas tillgänglig på engelska för att vidga träffyta för utrikesfödda. Tack För en riktigt bra utbildning"
- "Jag tycker detta var en bra och heltäckande utbildning. Trots att jag jobbat med frågorna tidigare fick jag flera nya vinklar att se på olika saker. Det är inte alltid så självklart"
- "Jag tycker du gjort denna utbildning bra, och väldigt bra att man kan ladda ner mallar"
- "Bra genomgång med exempel som är lätta att förstå för utbildningen"
Du lär dig att göra en faroanalys och riskbedömning baserat på Codex Alimentarius samt varianter baserade på BRC, ISO 22 000 och FSSC 22 000 och du får användbara mallar som du kan jobba med.
Kursmaterial består av Videos, Åhörarkopior, Övningsuppgifter och Kunskapsprov.
Vibrio-infektion - köttätande bakterien som
orsakar dödliga livsmedelsburna sjukdomar

Vad är Vibrio?
Vibrio är en bakterie som naturligt lever i vissa kustvatten. De finns i större antal i maj till oktober, när vattentemperaturerna är varmare.
Kustvatten inkluderar saltvatten och bräckt vatten. Bräckt vatten är en blandning av saltvatten och sötvatten. Den finns ofta där floder möter havet.
Hur får man vibrios?
De flesta människor får vibrios av att äta råa eller dåligt tillagade skaldjur, särskilt ostron.
En del får vibrios efter att ett öppet sår kommit i kontakt med kustvatten.
Hur farligt är det?
Många personer med Vibrio vulnificus-infektion kan bli allvarligt sjuka och behöva intensivvård eller amputation av extremiteter. Ungefär 1 av 5 personer med denna infektion dör, ibland inom en dag eller två efter att de blivit sjuka.
Hexanrester upptäckta i vardagliga livsmedel:
fransk undersökning väcker oro

En nyligen genomförd undersökning i Frankrike har avslöjat oroande resultat om förekomsten av hexan, ett petroleumbaserat lösningsmedel, i olika animaliska produkter och oljor som vanligtvis konsumeras av allmänheten. Denna studie omfattade analyser utförda av två oberoende laboratorier (Joint Measurement Center vid University of the Opal Coast och en privat testanläggning). Resultaten visade att nästan hälften av de 54 testade livsmedelsprodukterna, inklusive oljor, margariner, smör, ägg och kyckling, innehöll detekterbara nivåer av hexanrester.
Hexan används främst inom livsmedelsindustrin för att effektivt utvinna oljor från frön som sojabönor, solrosor och rapsfrön. Även om denna extraktionsprocess är kostnadseffektiv kan den lämna efter sig rester av hexan i oljorna, som därefter kan komma in i livsmedelskedjan. Undersökningen visade att 25 av de 54 produkter som provtogs uppvisade hexanförorening, vilket väckte farhågor om att detta problem var utbrett.
Lär dig mer - System för TACCP och VACCP
(Hot, Sabotage och Förfalskning)

Må kiwikraften vara med dig

Ett nytt och otroligt tilltalande hälsopåstående har godkänts av Europeiska myndigheten för livsmedelssäkerhet, EFSA, för grön kiwi (Actinidia deliciosa "Hayward")
Påståendet är: "Konsumtion av grön kiwi bidrar till normal tarmfunktion genom att öka avföringsfrekvensen"
Påståendet, som är godkänt enligt förordning EU 2025/1560, kan endast användas för:
i) färska gröna kiwifrukter som säljs som sådana, eller
ii) färska gröna kiwifrukter som endast har skalats och/eller skurits, med en vikt på minst 200 g kiwifruktkött, med information till konsumenterna om att detta är den mängd som behövs för att uppnå den taumaturgiska effekten
FSIS Guidelines - Nya HACCP modeller

FSIS har kommit med två nya HACCP -modeller för:
HACCP-modell för ätfärdiga fermenterade, salthärdade och torkade produkter (ej värmebehandlade – lagringsstabila)
HACCP-modell för pastöriserat flytande ägg (helt kokt - ej hyllstabil kategori)
Fågelinfluensa i mejeriprodukter

I the Rotten Apple gör Karen Constable en mycket bra översikt över spridningen av Fågelinfluensa bland mjölkkor i USA.
Från och med september 2025 har viruset bekräftats i över 1 000 besättningar i 17 delstater, inklusive Kalifornien, Idaho, Colorado och Texas. Testning av prover av rå (opastöriserad) mjölk, som samlats in från silor vid mejeribearbetningsanläggningar, utförs av USDA som en del av dess nationella strategi för mjölktestning.
Mjölk som innehåller smittsamma viruspartiklar kan potentiellt överföra sjukdomen till människor både via luftvägarna (genom inandning medan man äter/dricker) och genom mag-tarmkanalen.
Pastörisering verkar inaktivera viruset, vilket gör pastöriserade mejeriprodukter säkra. Lagrade hårdostar som tillverkas av opastöriserad mjölk som innehåller viruset kan också vara säkra, och forskning pågår.
Investera i utbildning och kompetens On-line
Öka din kompetens genom att gå någon av mina prisvärda Online-utbildningar.
Du anmäler dig på hemsidan eller vill du hellre ha faktura så skicka epost till mig
- Du har tillgång till utbildningen så länge den finns kvar på webben eller tidsbegränsat för vissa kurser
- Du kan se den hur många gånger som helst
- Använd PC, Mac, smartphone eller läsplatta
- Du kan pausa och starta och sluta när det passar
- Du slipper resa och frånvaro
- Utbildningarna är uppdelade i flera avsnitt
- Ingår åhörarkopior, övningsuppgifter mm som vid andra kurser, som du enkelt laddar hem
- Intyg över genomförd utbildning


